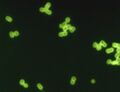
تصغير للنسخة بتاريخ 22:15، 3 ديسمبر 2023

ملف:Pneumococcus CDC PHIL ID1003.jpg
Pneumococcus_CDC_PHIL_ID1003.jpg (602 × 464 بكسل حجم الملف: 29 كيلوبايت، نوع MIME: image/jpeg)
وصف قصير
| Description |
English: Streptococcus pneumoniae in spinal fluid. FA stain (digitally colorized). Streptococci
Polski: Obraz w mikroskopie fluorescencyjnym, widać obraz dwoinek.
قالب:Ro |
| Date | 1964 |
| Source | قالب:CDC-PHIL |
| Author |
|
| ⧼wm-license-information-permission⧽ (⧼wm-license-information-permission-reusing-text⧽) |
PD-USGov-HHS-CDC English: None - This image is in the public domain and thus free of any copyright restrictions. As a matter of courtesy we request that the content provider be credited and notified in any public or private usage of this image. |
ترخيص
تاريخ الملف
اضغط على زمن/تاريخ لرؤية الملف كما بدا في هذا الزمن.
| زمن/تاريخ | صورة مصغرة | الأبعاد | مستخدم | تعليق | |
|---|---|---|---|---|---|
| حالي | ★ مراجعة معتمدة 22:15، 3 ديسمبر 2023 | | 602 × 464 (29 كيلوبايت) | Pastakhov (نقاش | مساهمات) | Upload https://upload.wikimedia.org/wikipedia/commons/9/9f/Pneumococcus_CDC_PHIL_ID1003.jpg |
لا يمكنك استبدال هذا الملف.
وصلات
لا يوجد صفحات تصل لهذه الصورة.
